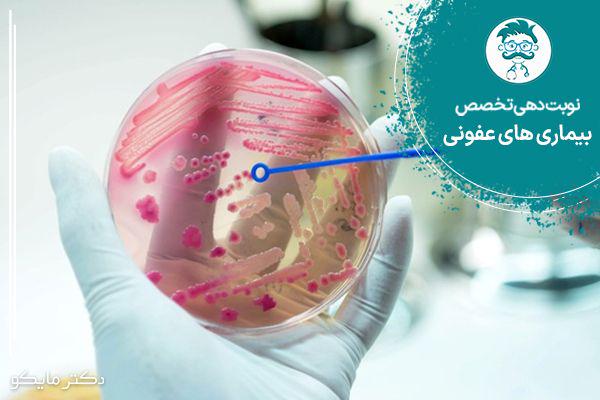
نوبت دهی متخصص عفونی

فارسیPersian
فارسیPersian انگلیسیEnglish
انگلیسیEnglish عربیArabic
عربیArabic- بستن
- تغییر زبان
- فارسی
- english
- عربی

- دریافتاپلیکیشن دکتر مایکو
- دانلود
فیلتر ها
- در حال بارگذاری...
در حال بارگذاری...
در حال بارگذاری...
- همه مراکز
سایر تخصص ها
ثبت نوبت دهی اینترنتی متخصص عفونی
با افزایش آلودگی های محیطی بیماری های عفونی و واگیردار بیشتر از پیش در جامعه گسترش یافته است. سامانه نوبت دهی اینترنتی دکترمایکو با سریع ترین روش نوبت دهی اینترنتی در تلاش است بیماران محترم هرچه سریع تر به نزدیکترین نوبت پزشک متخصص عفونی دسترسی داشته باشند. دکترمایکو با ثبت نوبت بهترین دکترهای متخصص عفونی از کلینیک ها و بیمارستان ها و مطب ها، آماده ارائه بهترین خدمات پزشکی به مراجعان محترم است.

ثبت نوبت سریع و ارزان
ثبت نوبت مقرون به صرفه و راحت از طریق گوشی همراه/لب تاپ متصل به اینترنت

انتخاب مطمئن پزشک برتر
امکان مقایسه خدمات و امتیازات پزشکان براساس نظر سایر بیماران پیش از ثبت نوبت

پشتیبانی همیشه همراه!
اطلاع رسانی پشتیبانی دکترمایکو درصورت ایجاد مشکل در مورد تاخیر یا لغو نوبت بیمار
متخصص عفونی کیست؟
متخصص بیماری های عفونی، پزشک متخصصی است که بر تشخیص و درمان بیماری های حاد و مزمن ناشی از باکتری ها، ویروس ها، قارچ ها، انگل ها و حتی پریون ها تمرکز دارد. متخصص عفونی در یک کلینیک یا بیمارستان کار می کند و بیماران زیادی از بخش های مختلف پزشکی به متخصص عفونی ارجاع داده می شوند.
با مراجعه به سامانه نوبت دهی اینترنتی دکترمایکو می توانید با سریع ترین روش نوبت اینترنتی خود را ثبت کنید.
متخصص عفونی چه بیماری هایی را درمان می کند؟
متخصص عفونی گروه متنوعی از بیماریها را تشخیص داده و درمان می کند که اصلی ترین آن ها سل، HIV، ویروسهای هپاتیت، مالاریا و عفونتهای قارچی همچنین عفونت هایی از جمله تب زرد، سیاه زخم، جذام و طاعون هستند. حوزه بیماری های عفونی همچنین شامل بیماری های جدید و نوظهور مانند ابولا، تب چیکونگونیا، آنفولانزای مرغی و کووید-19 می شود.
سامانه نوبت دهی اینترنتی دکترمایکو با بهترین پزشکان متخصص دکترعفونی آماده ارائه بهترین خدمات از بهترین پزشکان برای بهبود هرچه زودتر مراجعان محترم است.
متخصص عفونی چه کاری انجام می دهد؟
متخصص عفونی بیماریهای عفونی را بررسی میکند تا به سوال چگونه پاتوژنهایی مانند ویروسها و باکتریها باعث ایجاد بیماری میشوند پاسخ دهد. دکترعفونی توانایی جلوگیری از گسترش بیماری را دارد. همچنین می تواند جهت پیشگیری و کنترل بیماری های عفونی راه های درمانی را تجویز کند. با ثبت نوبت اینترنتی در سامانه نوبت دهی دکترمایکو نزدیکترین نوبت را برای درمان سریع تر بیماری خود دریافت نمایید.
متخصص عفونی کجا کار می کند؟
متخصص عفونی معمولا بیشتر وقت خود را در بیمارستان ها با بیماران می گذراند. دکتر عفونی معمولا از نزدیک با تیم هایی از پزشکان دیگر و پرستاران و دانشمندان آزمایشگاهی کار می کند. برخی ازپزشکان متخصص عفونی به عنوان میکروبیولوژیست در آزمایشگاه ها فعالیت می کنند.
با ثبت نوبت دهی اینترنتی از متخصصان عفونی دکترمایکو به بهترین پزشکان متخصص عفونی دسترسی خواهید داشت.
چه زمانی باید به متخصص بیماری های عفونی مراجعه کرد؟
همه کسانی که بیماری عفونی دارند به متخصص عفونی نیاز ندارند. اما گاهی اوقات برای تشخیص یا مدیریت بیماری های عفونی خاص به متخصص عفونی نیاز است. معمولا با وجود علائم زیر باید به متخصص عفونی مراجعه کنید:
- تب (گاهی اوقات تنها نشانه عفونت است)
- لرز و عرق کردن
- تغییر در سرفه یا سرفه جدید
- گلو درد یا زخم جدید دهان
- تنگی نفس
- گرفتگی بینی
- گرفتگی گردن
برای درمان بیماری های عفونی خود در کوتاه ترین زمان ممکن به سامانه نوبت دهی اینترنتی دکترمایکو مراجعه کنید.
بهترین متخصص عفونی را چگونه پیدا کنم؟
همیشه پیدا کردن بهترین متخصص در هر زمینه ای سخت است. سامانه نوبت دهی اینترنتی دکترمایکو لیستی از بهترین پزشکان متخصص عفونی را برای بیماران گردآوری کرده است. بیماران محترم می توانند با مراجعه به صفحه هر پزشک در سامانه نوبت دهی دکترمایکو امتیازات کسب شده هر متخصص را که توسط بیماران دیگر ثبت شده است مشاهده و بهترین متخصص موردنظر را برای ثبت نوبت خود انتخاب کنند.
مقالات مرتبط

- دریافتاپلیکیشن دکتر مایکو
- دانلود
- درباره دکتر مایکو
دکترمایکو از سال 1395 فعالیت خود را آغاز کرده است و هماکنون بیش از 100.000 کاربر دارد. این شرکت دانش بنیان با اتکا بر تواناییِ متخصصان جوان و داخلی، پلتفرم سلامت دیجیتال با مجوز رسمی را در قالب اپلیکیشن و وبسایت دکتر مایکو پیادهسازی کرده است.
- ارتباط با دکتر مایکو
تلفن پشتیبانی: 09423941000 و 8-05137059917
درباره ما
ارتباط با ما
تمامی حقوق مادی و معنوی این سایت متعلق به شرکت فناوری های متین آسمان پارس می باشد